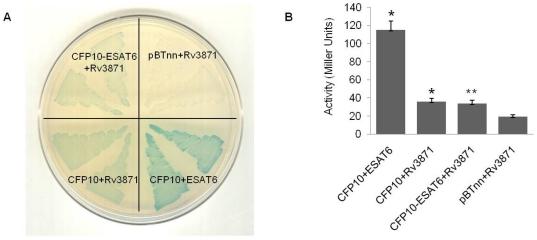

一种用于探测体内蛋白质-蛋白质相互作用的三杂交系统:在结核分枝杆菌 RD1 复合物的必需蛋白中的应用。
A three-hybrid system to probe in vivo protein-protein interactions: application to the essential proteins of the RD1 complex of M. tuberculosis.
机构信息
Recombinant Gene Products Group, International Centre for Genetic Engineering and Biotechnology, Aruna Asaf Ali Marg, New Delhi, India.
出版信息
PLoS One. 2011;6(11):e27503. doi: 10.1371/journal.pone.0027503. Epub 2011 Nov 8.
BACKGROUND
Protein-protein interactions play a crucial role in enabling a pathogen to survive within a host. In many cases the interactions involve a complex of proteins rather than just two given proteins. This is especially true for pathogens like M. tuberculosis that are able to successfully survive the inhospitable environment of the macrophage. Studying such interactions in detail may help in developing small molecules that either disrupt or augment the interactions. Here, we describe the development of an E. coli based bacterial three-hybrid system that can be used effectively to study ternary protein complexes.
METHODOLOGY/PRINCIPAL FINDINGS: The protein-protein interactions involved in M. tuberculosis pathogenesis have been used as a model for the validation of the three-hybrid system. Using the M. tuberculosis RD1 encoded proteins CFP10, ESAT6 and Rv3871 for our proof-of-concept studies, we show that the interaction between the proteins CFP10 and Rv3871 is strengthened and stabilized in the presence of ESAT6, the known heterodimeric partner of CFP10. Isolating peptide candidates that can disrupt crucial protein-protein interactions is another application that the system offers. We demonstrate this by using CFP10 protein as a disruptor of a previously established interaction between ESAT6 and a small peptide HCL1; at the same time we also show that CFP10 is not able to disrupt the strong interaction between ESAT6 and another peptide SL3.
CONCLUSIONS/SIGNIFICANCE: The validation of the three-hybrid system paves the way for finding new peptides that are stronger binders of ESAT6 compared even to its natural partner CFP10. Additionally, we believe that the system offers an opportunity to study tri-protein complexes and also perform a screening of protein/peptide binders to known interacting proteins so as to elucidate novel tri-protein complexes.
背景
蛋白质-蛋白质相互作用在使病原体在宿主中存活方面起着至关重要的作用。在许多情况下,相互作用涉及蛋白质复合物而不仅仅是两个给定的蛋白质。对于像结核分枝杆菌这样能够成功在巨噬细胞的恶劣环境中生存的病原体来说尤其如此。详细研究这些相互作用可能有助于开发出破坏或增强相互作用的小分子。在这里,我们描述了基于大肠杆菌的细菌三杂交系统的开发,该系统可有效地用于研究三元蛋白质复合物。
方法/主要发现:结核分枝杆菌发病机制中涉及的蛋白质-蛋白质相互作用已被用作三杂交系统验证的模型。在我们的概念验证研究中,使用结核分枝杆菌 RD1 编码的蛋白质 CFP10、ESAT6 和 Rv3871,我们表明在 ESAT6 存在下,CFP10 和 Rv3871 之间的相互作用得到加强和稳定,ESAT6 是 CFP10 的已知异二聚体伴侣。该系统还提供了另一种应用,即分离能够破坏关键蛋白质-蛋白质相互作用的肽候选物。我们通过使用 CFP10 蛋白作为先前建立的 ESAT6 和小肽 HCL1 之间相互作用的破坏者来证明这一点;同时我们还表明 CFP10 不能破坏 ESAT6 与另一个肽 SL3 之间的强相互作用。
结论/意义:三杂交系统的验证为寻找比其天然伴侣 CFP10 更强的 ESAT6 结合肽铺平了道路。此外,我们相信该系统为研究三蛋白复合物提供了机会,并且还可以对已知相互作用蛋白的蛋白质/肽结合物进行筛选,以阐明新的三蛋白复合物。